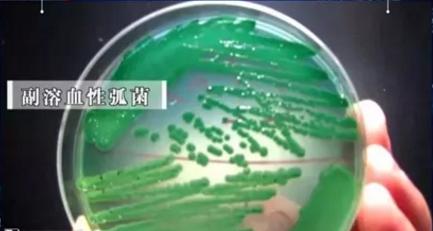
冰箱除菌除味最好的方法,冰箱除菌除味方法

天气一热,人们就喜欢贪凉,不管什么食物都想搁到冰箱里凉一凉再吃。但你有没有发现,打开冰箱后,似乎总能闻到一股隐隐约约的异味,有时候连水果上都被沾染了,吃起来怪怪的。明明冰箱里的食物没有发生变质腐烂,怎么就产生异味了呢?吃了有异味的食物会不会伤身体?今天,就带你去探秘冰箱~

冰箱异味,可能是细菌“作怪”
很多食物都有自己特殊的气味,比如香菜、芹菜、榴莲等;烹饪过的菜肴又具有独特的香味。如果这些食物都没有密封放置,多种味道组合在一起,就可能形成奇奇怪怪的味道。
除此之外,冰箱异味很可能是细菌在“作怪”!
冰箱能保鲜,但不能“杀菌”,一些不怕冷的细菌可以在冰箱大量繁殖生长。德国科学家研究发现,家用冰箱平均每平方厘米约有1140万个细菌!

这些细菌靠着食物的营养生长代谢,在此过程中,会产生许多发臭的气体,比如:臭鸡蛋味的硫化氢、脚臭味的甲硫醇、咸鱼味的甲基胺等等。
不过,比起难闻的气味,我们更该警惕的是细菌暗藏的健康威胁,如果吃了被它们污染的食物,很可能诱发疾病,甚至危及生命,尤其下面几种细菌更危险!
1、李斯特菌
李斯特菌感染事件,时常发生:
- 今年3月,美国爆发李斯特菌感染致4死,30人住院;
- 2019年12月,美国5个州7人感染了李斯特菌,其中有4人住院,1人死亡;
- 2019年,澳大利亚食物中毒事件激增 食安委提醒注意李斯特菌感染……
李斯特菌是嗜冷菌,在寒冷的冰箱里也能生长并大量繁殖,肉类尤其是牛肉很容易滋生李斯特菌,而后会污染周围的水果、开封饮品等,甚至整个冰箱都不能幸免。
有研究表明,被李斯特菌感染的人群,家中的冰箱三分之二都被李斯特菌污染了。其中,孕妇、婴儿、老年人等免疫力较低的人群更容易受到威胁。
当我们不小心感染李斯特菌后,可能在3~70天内出现腹泻+高热+疼痛的典型症状,但也有可能伴有恶心、呕吐、腹部痉挛、头痛、便秘等,严重时还可能引发流产、肾炎、脑膜炎、败血症等,甚至导致死亡。

如何远离李斯特菌
- 定期清理冰箱;
- 李斯特菌在70℃下2分钟即可灭活,所以食物最好充分加热。
2、沙门氏菌
沙门氏菌广泛存在于肉、鸡、蛋壳等地方,在冰箱的存活时间能多达2~3个月。它是引起细菌性食物中毒最常见、比例最大的致病菌,有数据显示,全世界每年有6亿人因为食用被它污染的食物而患病。
沙门氏菌主要危害胃肠道,表现为肚子绞痛、上吐下泻,有时伴随发烧。很多人感染沙门氏菌后可能两三天就好了,但对于免疫力低下或体质较弱的人,就可能“不堪重负”,甚至出现脏器衰竭。

如何远离沙门氏菌
- 生、熟分开切、存放;
- 沙门氏菌很怕热,在100℃下瞬间就会被灭活,建议食物煮熟食用,尽量少吃溏心蛋等半熟制品;
- 接触可能含有沙门氏菌的食物后,应立即洗手,避免接触生菜、水果等即食食品。
3、副溶血性弧菌
副溶血性弧菌虽是海洋细菌,但也可能存在于买回来的海产品中。
之前有节目曾走访了三户人家,对他们家中冰箱里冷冻的带鱼进行了取样检测,发现其中2户人家的带鱼都含有副溶血性弧菌。
它可以通过消化道感染人体,引起腹痛、呕吐、腹泻等症状;也能通过血液感染人体,比如处理海鲜时不小心划破了手,细菌就可能通过伤口进入血液,破坏红细胞,引发溶血,甚至致死。因其危害大,也有“现代霍乱”之称。
如何远离副溶血性弧菌
- 副溶血性弧菌怕酸,用白醋处理海鲜不仅能杀灭部分副溶血性弧菌,还有助于去除海鲜的部分腥味,再用高温加热,就可以放心吃了。
- 如果被海鲜划伤手,切记不可用生理盐水处理伤口,以免加速细菌繁殖。
4、志贺氏菌
志贺氏菌就是我们常说的痢疾杆菌,能污染肉类、蛋类、牛奶、海产品等食物,却很耐寒,能在冰块中存活2个月之久。
食用痢疾杆菌污染的食物或饮水后导致了感染,一般24~48小时内发病,引发剧烈腹痛、腹泻、呕吐、发烧等不适,也可能导致休克。而且由于抗生素的广泛使用,其耐药性不断增加,加大了治疗困难。

如何远离志贺氏菌
- 志贺氏菌对加热以及化学消毒剂的抵抗力较弱,一般56~60℃经10分钟即可灭活。
5、耶氏菌
耶氏菌可能少有人知,但到处都有它的“身影”,包括几乎所有的猪、牛、羊、鸡、鸭等动物,蛋类、豆类、牛奶等也可受到污染,它在冰箱中也能存活1~2个月。
人如果吃了被耶氏菌污染的食物,可能出现腹痛、腹泻、发烧等症状,粪便呈黄色水样或含黏液,每日3~10次不等,病程可持续1~2周,有的可长达3个月,甚至进展为慢性特发性肠炎、慢性结肠炎。它还可以引起脑膜炎、脑脓肿、肝脓肿、败血症等严重后果。

如何远离耶氏菌
- 60℃保持30分钟,或100℃保持5分钟,可杀灭耶氏菌。
虽然冰箱内可能细菌众多,但也不用太过于担心,强大的免疫系统能帮助消灭一些进入人体的细菌。但免疫力较低的人群,则需要多加警惕,能加热的尽量充分加热,不能加热的要储存得当,并少吃冷食。
减少细菌污染,4个使用注意事项
生活中,很多人把冰箱当“保险箱”,不管什么食物都往冰箱里塞,不仅满满当当,还可能乱七八糟。但这些不在意的小细节,很可能导致细菌大量繁殖,让冰箱变成“细菌窝”。怎样才能减少冰箱细菌威胁?

01
食物储存有期限
不少家庭的冰箱中都有“存货”,比如:半个月前的苹果、半年前的冷冻肉等等。绝大多数食物都或多或少含有一些细菌,如果冰箱的环境适宜它们生长,时间一长,细菌就会利用食物中的营养成分越长越多,还会导致食物变质腐烂。
那么,不同的食物在冰箱内最多可以储存多久?大家可以参照下表:

此外,有些食物不建议放冰箱,否则可能坏得更快或影响口感,比如:
◎部分蔬菜:叶类蔬菜即便冷藏也容易烂,最好不要挨着冰箱内壁,以免冻伤;西红柿、黄瓜、青椒等被冷冻后容易变软、变黑,且黄瓜、青椒容易被冻发黏,所以不宜放进冰箱。
◎蜂蜜:低温下,蜂蜜中的结晶会析出葡萄糖,影响口感。建议密封存放在阴凉处即可。
◎巧克力:放进冰箱的巧克力在拿出来后,表面容易出现白霜,不但失去原来的醇香口感,还会利于细菌的繁殖。
◎中药材:中药材放冰箱里,很容易受潮、变质,影响药性,甚至引发副作用。

02
存储位置很关键
①巧用不同区域温度差
◎冷藏区:温度为0-4℃左右,适合存放剩饭剩菜、水果蔬菜等;
◎恒温冷藏区:也就是抽屉那层,温度为0℃,适合存放鸡蛋、即将吃掉或解冻的肉类;
◎冰箱门:因为经常开合,温度较高,在6℃左右,适合放密封包装的饮料、乳品、酱料等。

②熟食在上,生食在下
微生物也会沉降,也就是说,细菌是往下走的。而熟食细菌较少,所以应该用保鲜膜或保鲜盒密封放上层,往下依次放半熟食品、生食,有利于避免细菌交叉污染。无论是冷藏室还是冷冻室,都应该遵循这个原则。

03
冰箱温度有讲究
冰箱冷藏室和冷冻室的温度也有讲究,一般冷藏室的温度设置在5℃以下,冷冻室设置在-18℃左右较佳,有利于抑制食物中致病菌的生长和繁殖,更好地发挥食物保鲜的作用。

04
食物储存有期限
冰箱塞太满,空气无法正常循环,会导致冰箱温度升高,促进细菌生长繁殖,还会加快食物的腐败 。一般来说,冰箱最多放七成满。

做好冰箱清洁,清除细菌少异味
即便是正确使用冰箱,时间久了也难免存在很多细菌,尤其是隔板、蔬菜区、蛋肉区等。所以,除了定期清理冰箱中的食物,经常灭菌很重要,不仅更健康,也没有异味。但冰箱清洁具体应该怎么做?
01
合理使用保鲜盒

无论是剩饭剩菜、各种调味酱等熟食,还是水果、需要解冻的肉类等,都应该用保鲜盒或保鲜膜独立密封保存,既有助于防止串味,也有助于减少细菌繁殖及交叉污染。
02
定期清洁冰箱,做好杀菌工作

◎酒精+食醋:建议每隔1~2个月用浓度70%的酒精+食醋清洁冰箱,再用清水洗净。
◎酒精+可乐:将酒精和可乐按照1:1的比例兑好,用吸水性强的纱布或纸缠绕在叉子上,蘸取溶液清理冰箱门上缝隙,可有效清除霉菌。
【注意】不建议使用洗洁精或其他消毒剂,以免清洁不到位反而导致不必要的健康风险。
03
冰箱除味小技巧

◎芳香食物:如:柠檬、柚子皮等,本身具有比较浓郁的香味,将它们切片放在冰箱偏下层的角落里,有助于去除异味。要记得每隔一段时间更换哦。
◎活性炭等用品:活性炭有一定的吸附作用,可帮助去除异味。
